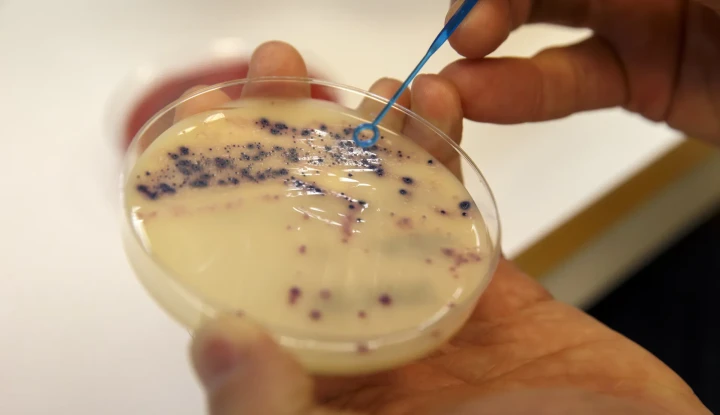
zanti1

Nytt vapen mot antibiotikaresistens
Multiresistenta bakterier. I Sverige och globalt blir resistenta bakterier, som antibiotika inte biter på, allt fler. När antibiotikan inte fungerar blir det svårare att behandla sjukdomar som orsakats av bakterier, som hjärnhinneinflammation och lunginflammation. Bild: Cornelius Poppe/NTB/TT
Forskare vid Karolinska institutet har hittat ett sätt som skulle kunna få antibiotika att bekämpa resistenta bakterier, rapporterar SVT Nyheter.
En ny studie vid KI har nu visat att möss som infekterades med penicillinresistenta pneumokocker och drabbades av hjärnhinneinflammation blev helt friska sedan de fått antibiotika i kombination med enzymet endolysin. Enzymet, som kommer från bakteriofager, det vill säga virus som dödar bakterier, fick antibiotikan att börja fungera igen.
Nu är forskarnas förhoppning att i framtiden kunna använda metoden för att behandla hjärnhinneinflammation även hos människor.
– Patienterna behöver få effektiv behandling inom max två dagar, annars uppstår allvarliga neurologiska komplikationer eller till och med död, säger Federico Iovinos, docent i medicinsk mikrobiologi vid KI, till SVT.
Forskarna ska nu undersöka endolysins effekt på flera olika slags resistenta bakterier.